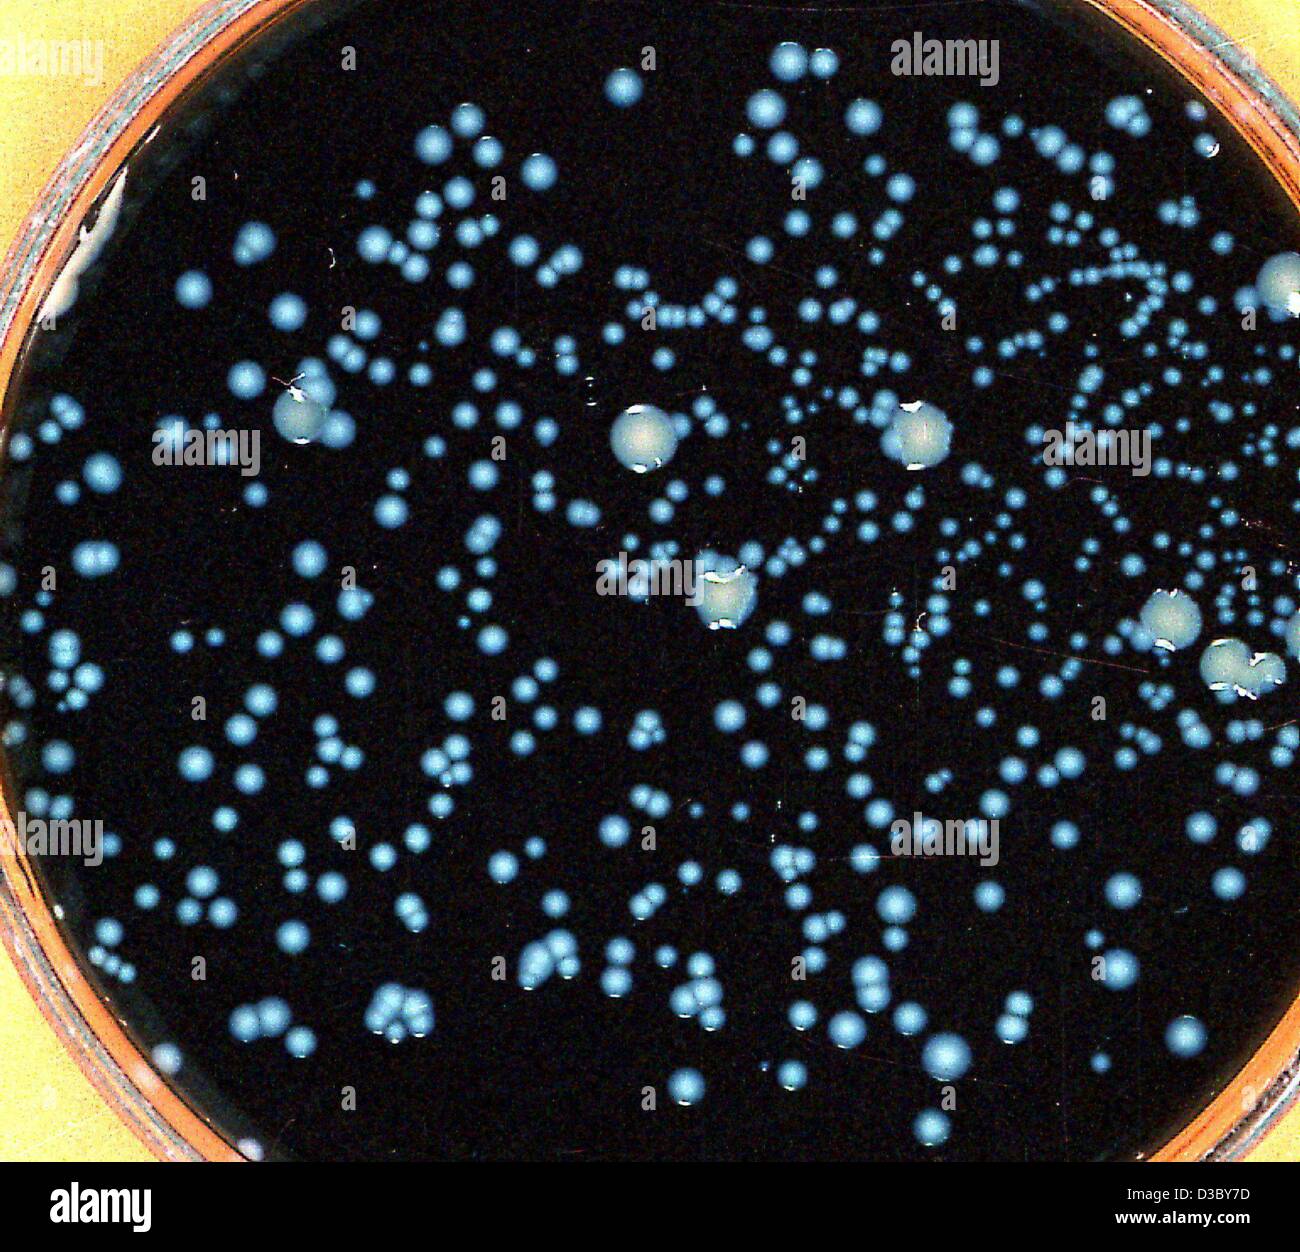
(Dpa file) - Un filer non datata rilasciato dall'Università tecnica di Dresda, in Germania, mostra una colonia del batterio Legionella pneumophila, che può provocare il cosiddetto morbo del legionario, su un supporto di carbone. La diffusione di batteri soprattutto nella scarsa manutenzione dei tubi dell'acqua, acqua calda s Foto Stock

Legionnaires disease Immagini Stock
(368)Filtri rapidi:
Legionnaires disease Immagini Stock

RFMYDRGG–Le legionelle batteri. Computer illustrazione della Legionella pneumophila batteri, la causa del morbo del legionario. Questi bacilli (a forma di asta batteri) sono Gram-negativi. L. pneumophila è stato identificato come un agente patogeno (agente della malattia) dopo una misteriosa epidemia di polmonite causato 29 morti in un American Legion convenzione nel 1976. Questo batterio è stato trovato che vivono in serbatoi di acqua, i bagni dispongono di doccia a telefono e sistemi di aria condizionata. La malattia provoca pneumonic irreversibili danni ai polmoni negli anziani e inadatti.

RF3CDM7DC–Malattia dei legionari e Legionella pneumophila batteri focolaio e malattia respiratoria come una forma grave di polmonite come una microbiologia patologica A.

RFPBBP1P–Le legionelle, concettuale illustrazione del computer. Legionella pneumophila i batteri sono la causa del morbo del legionario. Questi bacilli (a forma di asta batteri) sono Gram-negativi. L. pneumophila è stato identificato come un agente patogeno dopo una misteriosa epidemia di polmonite causato 29 morti in un American Legion convenzione nel 1976. Questo batterio è stato trovato che vivono in serbatoi di acqua, i bagni dispongono di doccia a telefono e sistemi di aria condizionata. La malattia provoca pneumonic irreversibili danni ai polmoni negli anziani e inadatti.

RM2BE0H4H–Micrografia elettronica a scansione (SEM) con Legionella pneumophila su biofilm; ingrandimento: 3200X. Questo organismo è l'agente causativo della malattia dei Legionnaires.

RF2FM2W34–Malattia di Legionaires polmonite atipica causata da batteri Legionella. Segni e sintomi della malattia. Primo piano dei polmoni con polmonite grave

RF2H5RKDP–La rappresentazione della malattia di Legionnaires ha mostrato un modello di legno che spinge il peso pesante per simbolizzare la lotta e il dolore quando si tratta della malattia di Legionnaires, 3d

RM2J8GREG–Una foto del 1977 di una donna che indossa un marchio chirurgico durante lo scoppio della malattia di Legionnaires a New York City

RF2H5PMAX–L'impatto della malattia di Legionnaires e l'influenza sociale mostrato come una figura in sacchoria per descrivere l'effetto della malattia di Legionnaires sulla salute umana e il suo significato

RF2D8RE96–LG unità di aria condizionata sul tetto della condominio, la Mata, Torrevieja, Costa Blanca, Spagna, inverno, sole invernale, destinazione

RMCMDK7E–Royal Stoke University Hospital Stoke on Trent North Staffs Staffordshire England Regno Unito

RF2M1HNXK–3D immagine di ossitetraciclina formula scheletrica - struttura chimica molecolare di antibiotico tetraciclina ad ampio spettro isolato su sfondo bianco

RM2BE0GNJ–Trasmissione micrografia elettronica (TEM) che mostra batteri nel genere Legionella, con vacuoli visibili. Questi batteri patogeni Gram-negativi causano la legionellosi o la disesasi di Legionnaires. Batteri su terreno batteriologico. Ingrandimento: 90.000 x a 35 mm.

RF2BABBGR–Paziente affetto da malattia infettiva, malato con syptoms.contagious disease painty.ll persona che ha letale malattia respiratoria.attaccato imm

RF3AP0KDY–Legionella pneumophila batteri focolaio e malattia respiratoria come malattia dei legionari una forma seria di polmonite come una patologia microbiologia ed e

RFPBBP1Y–Le legionelle, concettuale illustrazione del computer. Legionella pneumophila i batteri sono la causa del morbo del legionario. Questi bacilli (a forma di asta batteri) sono Gram-negativi. L. pneumophila è stato identificato come un agente patogeno dopo una misteriosa epidemia di polmonite causato 29 morti in un American Legion convenzione nel 1976. Questo batterio è stato trovato che vivono in serbatoi di acqua, i bagni dispongono di doccia a telefono e sistemi di aria condizionata. La malattia provoca pneumonic irreversibili danni ai polmoni negli anziani e inadatti.

RF3CDM8DB–I sintomi della malattia dei legionari e i batteri della Legionella pneumophila focolaio e la malattia respiratoria come una forma grave di polmonite come una microb patologica

RF3AHD5PR–Batteri Legionella pneumophila che causano malattie respiratorie come malattia dei legionari come una forma seria di polmonite come una microbiologia patologica

RM2HJCPCY–Questa radiografia anteroposteriore del 1976 ha rivelato infiltrati polmonari bilaterali in un paziente con malattia di Legionnaires. La malattia di Legionnaires è stata scoperta dopo un'epidemia ad una convenzione di Filadelfia della legione americana in 1976. È un tipo di polmonite causata dai batteri della Legionella pneumophila.

RM2HJCPC1–Gli scienziati George Gorman (a sinistra) e Jim Feeley nel 1978, esaminando le piastre di coltura su cui erano stati cresciuti i primi isolati ambientali di Legionella pneumophila. Agente causale della malattia di Legionnaires, questo batterio è stato scoperto quando è diventato responsabile di un focolaio ad una convenzione di Filadelfia della legione americana in 1976.

RMBMN721–Parabrezza auto acqua di lavaggio può essere la causa del 20% dei casi di morbo del legionario dice il Regno Unito Agenzia per la tutela della salute

RM2HJCPCN–Questa radiografia anteroposteriore del 1976 ha rivelato infiltrati polmonari bilaterali in un paziente con malattia di Legionnaires. La malattia di Legionnaires è stata scoperta dopo un'epidemia ad una convenzione di Filadelfia della legione americana in 1976. È un tipo di polmonite causata dai batteri della Legionella pneumophila. Colore ottimizzato.

RMF0BC8P–Una torre di raffreddamento sul tetto di un edificio in New York venerdì, 7 agosto 2015. In seguito al focolaio del morbo del legionario il New York City Dipartimento di Salute ha ordinato tutte le torri di raffreddamento in città per essere disinfettati entro due settimane. (© Richard B. Levine)

RM2HJCNRN–Legionnaires Disease ‚Äì The Great Hoax, a National Enquirer copertina titolo da ottobre 1977. La malattia di Legionnaires è in realtà abbastanza reale ed è stata scoperta dopo uno scoppio ad una convenzione di Philadelphia della legione americana in 1976. È un tipo di polmonite causata dai batteri della Legionella pneumophila.

RM2HJCNRC–Questa immagine del 1978 raffigura gli scienziati Charlotte Patton e Scott Johnson che esaminano un profilo di cromatografia gas-liquida degli acidi grassi cellulari prodotti dai batteri Legionella pneumophila. Agente causale della malattia di Legionnaires, questo batterio è stato scoperto quando è diventato responsabile di un focolaio ad una convenzione di Filadelfia della legione americana in 1976.

RF2BABB63–Donna malata che tiene tosse sanguinaria di tissutale.tosse con malattia infettiva di blood.Infectious vittima.ll persona che ha malattia respiratoria letale.attaccata sistema immunitario.Sympto

RFPBBP1T–Le legionelle, concettuale illustrazione del computer. Legionella pneumophila i batteri sono la causa del morbo del legionario. Questi bacilli (a forma di asta batteri) sono Gram-negativi. L. pneumophila è stato identificato come un agente patogeno dopo una misteriosa epidemia di polmonite causato 29 morti in un American Legion convenzione nel 1976. Questo batterio è stato trovato che vivono in serbatoi di acqua, i bagni dispongono di doccia a telefono e sistemi di aria condizionata. La malattia provoca pneumonic irreversibili danni ai polmoni negli anziani e inadatti.

RM2HJCPEK–La micrografia elettronica a scansione (SEM) di un certo numero di batteri Gram-negativi della Legionella pneumophila, la causa della malattia di Legionnaires. Ingrandimento: 12.000x.

RFMYDRGE–Le legionelle batteri. Computer illustrazione della Legionella pneumophila batteri, la causa del morbo del legionario. Questi bacilli (a forma di asta batteri) sono Gram-negativi. L. pneumophila è stato identificato come un agente patogeno (agente della malattia) dopo una misteriosa epidemia di polmonite causato 29 morti in un American Legion convenzione nel 1976. Questo batterio è stato trovato che vivono in serbatoi di acqua, i bagni dispongono di doccia a telefono e sistemi di aria condizionata. La malattia provoca pneumonic irreversibili danni ai polmoni negli anziani e inadatti.

RMG577JC–Una visione generale di Edimburgo, in quanto il numero di casi confermati di malattia di Legionaires a seguito di un focolaio mortale è aumentato.

RM2JA9K7C–Informazioni su un alto livello di contaminazione da Legionella nell'acqua potabile per i residenti di una casa, Berlino

RFEPRP4X–Eritromicina compresse, capsule, sospensioni e iniezione sono utilizzati per il trattamento di infezioni causate da batteri

RMBMN71E–Parabrezza auto acqua di lavaggio può essere la causa del 20% dei casi di morbo del legionario dice il Regno Unito Agenzia per la tutela della salute

RM2RHDW02–Persone che salgono sulla chiatta dell'alloggio Bibby Stockholm al porto di Portland nel Dorset dopo che è stata dichiarata sicura. I richiedenti asilo sono stati messi a bordo della chiatta lunedì scorsa settimana, ma sono stati rimossi venerdì dopo i test hanno rivelato la Legionella - i batteri che possono causare la malattia dei Legionari potenzialmente fatale. Data foto: Mercoledì 16 agosto 2023.

RM2A6JGCT–Una coppia di rubinetti in un ospedale del Regno Unito dotati di filtri speciali per legionella e controllo batterica.

RF2D8REC4–LG unità di aria condizionata sul tetto della condominio, la Mata, Torrevieja, Costa Blanca, Spagna, inverno, sole invernale, destinazione

RF2HDB9EG–Risultato del test Legionella con campione di sangue nella provetta mano del medico in laboratorio medico

RFME2BNY–Aria condizionata torre di raffreddamento unità in città, con edifici per uffici in background

RFMYDRGH–Le legionelle batteri. Computer illustrazione della Legionella pneumophila batteri, la causa del morbo del legionario. Questi bacilli (a forma di asta batteri) sono Gram-negativi. L. pneumophila è stato identificato come un agente patogeno (agente della malattia) dopo una misteriosa epidemia di polmonite causato 29 morti in un American Legion convenzione nel 1976. Questo batterio è stato trovato che vivono in serbatoi di acqua, i bagni dispongono di doccia a telefono e sistemi di aria condizionata. La malattia provoca pneumonic irreversibili danni ai polmoni negli anziani e inadatti.

RMCTXKD1–Reparto di emergenza e incidenti University Hospital North Staffordshire Stoke-on-Trent, Staffordshire, Inghilterra, Regno Unito

RF2C7J5FK–Illustrazione di un batterio della Legionella pneumophila, la causa della malattia di Legionaires. Questi bacilli (batteri a forma di barra) sono Gram-negativi. L. pneumophila è stato identificato come un patogeno (agente della malattia) dopo un misterioso focolaio di polmonite ha causato 29 morti ad una convenzione americana della Legione nel 1976. Questo batterio è stato trovato che vive in serbatoi d'acqua, soffioni e impianti di condizionamento d'aria. La malattia provoca danni polmonari polmonari fatali negli anziani e malessere.

RM2RHEGH5–Portland, Dorset, Regno Unito. 16 agosto 2023. Vista generale dall'aria della chiatta Bibby Stoccolma richiedenti asilo al porto di Portland vicino a Weymouth nel Dorset, evacuata la settimana scorsa dopo la scoperta di batteri della Legionella. La chiatta rimane libera mentre gli specialisti puliscono il sistema idrico per rimuovere i batteri nocivi che possono causare la malattia dei Legionari potenzialmente fatale. Foto: Graham Hunt/Alamy Live News

RM2BE0J9M–Le amebae vive (FLA) nel gruppo degli Amoebozoi sono cause importanti di malattie nell'uomo e negli animali. Microsografia elettronica a scansione (SEM) di un biofilm di acqua potabile coltivato in laboratorio, con presenza di cisti di Vermamoeba vermiformis (Hartmanella). I batteri acquatici sono stati coltivati come biofilm su acciaio per una settimana. V. vermiformis sono stati poi aggiunti, e fagocitizzati i batteri che si sono moltiplicati all'interno delle vescicole che sono diventate cisti in cui i batteri vivranno fino a che non si rompono. Vermamoeba vermiformis un'ameba libera (FLA), diffusa in natura ed isolata dal suolo, fresca

RM2JA9K7T–Informazioni su un alto livello di contaminazione da Legionella nell'acqua potabile per i residenti di una casa, Berlino

RM2BE0H4M–Le amebae vive (FLA) nel gruppo degli Amoebozoi sono cause importanti di malattie nell'uomo e negli animali. SEM di un biofilm di acqua potabile coltivato in laboratorio, con presenza di cisti di Vermamoeba vermiformis (Hartmanella). I batteri acquatici sono stati coltivati come biofilm su acciaio per una settimana. V. vermiformis sono stati poi aggiunti, e fagocitizzati i batteri che si sono moltiplicati all'interno delle vescicole che sono diventate cisti in cui i batteri vivranno fino a che non si rompono. Vermamoeba vermiformis un'ameba libera (FLA), è diffusa in natura ed è stata isolata dal suolo, dall'acqua dolce, dall'aria e da un

RMBMN6W5–Parabrezza auto acqua di lavaggio può essere la causa del 20% dei casi di morbo del legionario dice il Regno Unito Agenzia per la tutela della salute

RF2FMX5DB–Risultato del test Legionella con campione di sangue nella provetta mano del medico in laboratorio medico

RM2RHDW05–Persone che salgono sulla chiatta dell'alloggio Bibby Stockholm al porto di Portland nel Dorset dopo che è stata dichiarata sicura. I richiedenti asilo sono stati messi a bordo della chiatta lunedì scorsa settimana, ma sono stati rimossi venerdì dopo i test hanno rivelato la Legionella - i batteri che possono causare la malattia dei Legionari potenzialmente fatale. Data foto: Mercoledì 16 agosto 2023.

RF2K97862–3D immagine di Rifampicina formula scheletrica - struttura chimica molecolare di ansamicina antibiotico isolato su sfondo bianco

RMKR3G85–Le legionelle senato audizione durante lo scoppio degli anni settanta. Stati Uniti Sost. Elliott Levitas della Georgia del quinto quartiere congressuale a ?, 1977. Senato Audizione del morbo del legionario?. tenuto presso la CDC in 1977. Immagine cortesia CDC/Stafford Smith.

RM3A7EPK9–4 ottobre 2012 - Chicago, il, USA - Kent Carson lavora con la terapista occupazionale Sandy Kim presso il Rehabilitation Institute di Chicago il 4 ottobre 2012. Caron contrasse la malattia del Legionario e fece amputare tre arti. (Immagine di credito: © Jose M. Osorio/MCT/ZUMAPRESS.com)

RMK1F8X2–Questo microbiologo sta analizzando i sieri da indiretto colorazione con anticorpi per anticorpo di Legionella SPP Le legionelle ha acquisito il suo nome nel 1976 quando un focolaio di polmonite si è verificato tra le persone che frequentano una convenzione della legione americana di Philadelphia. Più tardi, il batterio provoca la malattia era denominato Legionella pneumophila . Immagine cortesia CDC/Warren Jones, 1979.

RFME2BTR–Aria condizionata torre di raffreddamento unità in città, con edifici per uffici in background

RMCTXKER–Incidenti e dipartimento di emergenza ospedale universitario Nord Staffordshire Stoke-on-Trent

RF2C7J5FE–Illustrazione dei batteri della Legionella pneumophila, la causa della malattia di Legionaires. Questi bacilli (batteri a forma di barra) sono Gram-negativi. L. pneumophila è stato identificato come un patogeno (agente della malattia) dopo un misterioso focolaio di polmonite ha causato 29 morti ad una convenzione americana della Legione nel 1976. Questo batterio è stato trovato che vive in serbatoi d'acqua, soffioni e impianti di condizionamento d'aria. La malattia provoca danni polmonari polmonari fatali negli anziani e malessere.

RM2RHEGFG–Portland, Dorset, Regno Unito. 16 agosto 2023. Vista generale dall'aria della chiatta Bibby Stoccolma richiedenti asilo al porto di Portland vicino a Weymouth nel Dorset, evacuata la settimana scorsa dopo la scoperta di batteri della Legionella. La chiatta rimane libera mentre gli specialisti puliscono il sistema idrico per rimuovere i batteri nocivi che possono causare la malattia dei Legionari potenzialmente fatale. Foto: Graham Hunt/Alamy Live News

RMBN3XWC–Micrografia elettronica a trasmissione che mostra la Legionella pneumophila moltiplicando i batteri all'interno di un umani coltivati fibroblasti di polmone

RF3CWA64N–Infezione da Legionella pneumophila, illustrazione. La Legionella pneumophila è un batterio Gram-negativo responsabile della malattia di Legionnaires’, una grave forma di polmonite.

RMBMN6X1–Parabrezza auto acqua di lavaggio può essere la causa del 20% dei casi di morbo del legionario dice il Regno Unito Agenzia per la tutela della salute

RMP2G205–Hutton, UK. Il 15 maggio 2018. BUPA £ 3 milioni di sterline per fini Hutton casa di cura di credito di morte: Ian Davidson/Alamy Live News

RM2RHDW0C–Persone che salgono sulla chiatta dell'alloggio Bibby Stockholm al porto di Portland nel Dorset dopo che è stata dichiarata sicura. I richiedenti asilo sono stati messi a bordo della chiatta lunedì scorsa settimana, ma sono stati rimossi venerdì dopo i test hanno rivelato la Legionella - i batteri che possono causare la malattia dei Legionari potenzialmente fatale. Data foto: Mercoledì 16 agosto 2023.
RMD3BY7D–(Dpa file) - Un filer non datata rilasciato dall'Università tecnica di Dresda, in Germania, mostra una colonia del batterio Legionella pneumophila, che può provocare il cosiddetto morbo del legionario, su un supporto di carbone. La diffusione di batteri soprattutto nella scarsa manutenzione dei tubi dell'acqua, acqua calda s

RFBY5ABE–Doccia sporca teste testa soffione doccia a telefono batteri igienico antigienico terreno fertile per i germi

RMD3BYBF–(Dpa) - un'ambulanza lascia la clinica "Klinikum Francoforte " a Francoforte sull'Oder, Germania orientale, 29 luglio 2003. Due donne sono morte a causa di una epidemia di legionelle in questo ospedale, e i funzionari sanitari detto 29 Luglio il bug sembrava aver preso in ospedale hot-tubi dell'acqua. La salute

RM3A7EPK2–4 ottobre 2012 - Chicago, il, USA - Kent Carson lavora con la terapista occupazionale Sandy Kim presso il Rehabilitation Institute di Chicago il 4 ottobre 2012. Caron contrasse la malattia del Legionario e fece amputare tre arti. (Immagine di credito: © Jose M. Osorio/MCT/ZUMAPRESS.com)

RMW57GKT–Un ospedale dotato di rubinetto con una T di sicuro medical toccare filtro descritto come comprendente lungo il ciclo di vita di grado sterilizzante membrana toccare filtro. Efficace contro contro batteri come legionella e altri. Regno Unito (111)

RM3C26BRC–2 maggio 2019 - Stockton, CALIFORNIA, USA - la California Health Care Facility, un ospedale penitenziario a sud di Stockton, California, ospita circa 2.600 detenuti, il 2 maggio 2019. Un paziente della prigione è morto a causa della malattia dei Legionari nel 2018, e i detenuti della struttura e due centri di correzione giovanile nelle vicinanze rimangono in acqua imbottigliata mentre il sistema idrico viene trattato. (Immagine di credito: © TNS via cavo ZUMA)

































